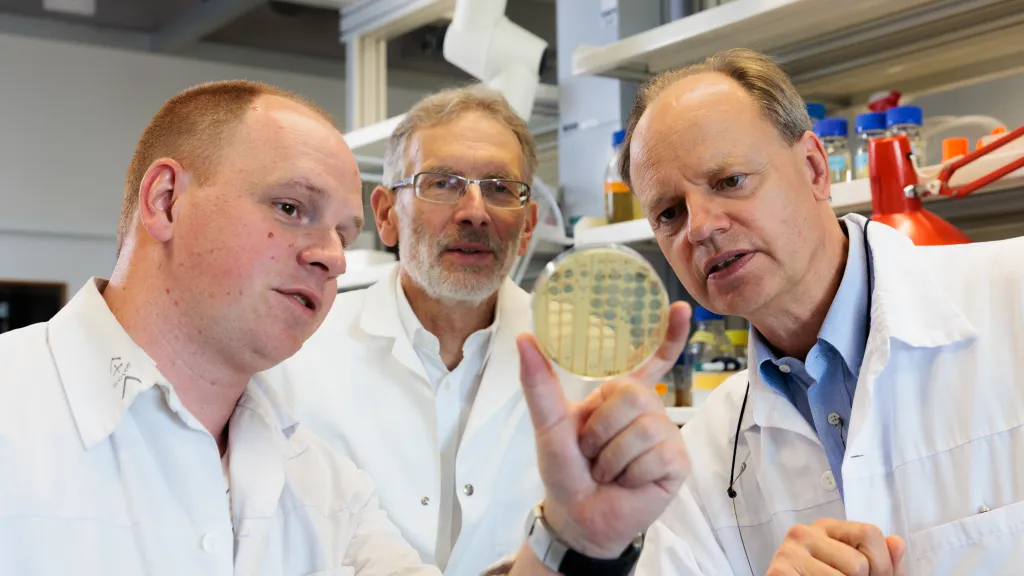
Bactériophages : De droite à gauche : Christian van Delden, Thilo Köhler et Alexandre Luscher - Copyright : Jonathan Imhof/ HUG

Vous avez activé la version contrastée du site. Pour plus d'infos à ce sujet veuillez consulter cette page.
Communiqués de presse
Le service des médias des HUG informe régulièrement les journalistes par le biais de communiqués, de dossiers et de conférences de presse.
Si vous êtes journaliste et souhaitez recevoir nos informations, inscrivez-vous à notre liste de diffusion.
Mardi 27 juin 2023
Antibiorésistance : un patient sauvé par les bactériophages
Lundi 12 juin 2023
Les HUG recherchent de nouveaux donneurs et donneuses de sang avant l'été
Lundi 08 mai 2023
60% du personnel des HUG est écomobile
Mercredi 26 avril 2023